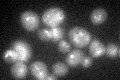
YGL212W
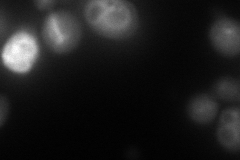
YGL212W
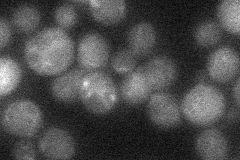
YGL212W
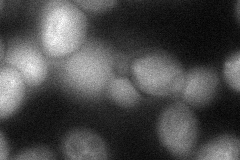
YGL212W
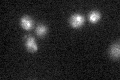
YGL212W

View description
Component of the vacuole SNARE complex involved in vacuolar morphogenesis; SNAP-25 homolog; functions with a syntaxin homolog Vam3p in vacuolar protein trafficking
Localization:
Intensity:
Fold change:
Significance:
-
C’ GFP library in SD
vacuole30.03 -
N' NOP1pr-GFP in SD

vacuole membrane79.3908 -
N' TEF2pr-mCherry in SD
vacuole membrane94.084 -
N' NATIVEpr-GFP in SD
below threshold20.9765 -
N' TEF2pr-VC and Cyto-VN in SD
cytosol,vacuole membrane44.7383 -
C’ GFP library in SD+DTT

vacuole28.780.95No -
C’ GFP library in SD+H2O2

vacuole29.310.97No -
C’ GFP library in Starvation Media
vacuole37.281.24No -
C’ GFP library on the background of Pup2-DaMP

vacuole -
C’ GFP library on the background of CCT mutant

vacuole24.5270.816417No
